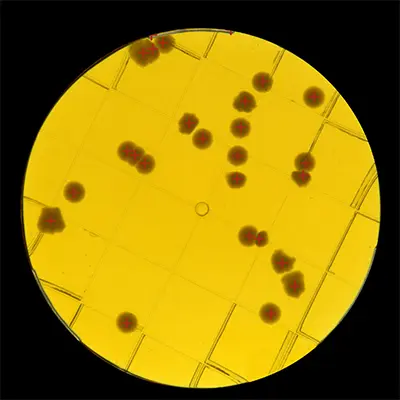

Discover how ScanStation can optimize the verification of environmental cleanness levels
Environmental monitoring (surface, air, water) plays a fundamental role in guaranteeing quality throughout the production process. Non-compliance can lead to batch losses, production delays and compromise consumer safety.
Reduce time-to-result
The analytical response time is crucial at each stage of production, especially in the event of a deviation where quick action is required.
Thanks to ScanStation technology, colonies are detected and counted as soon as they appear. ScanStation allows for real-time management and analysis of results, which is essential for quick decision making. The production risks associated with microbial contamination are significantly reduced. This risk management makes it a cost-effective solution for improving the quality and safety of your products.
Digitization of results

Traceability represents a real challenge for laboratories due to the complexity of the processes and the organization required to validate the results.
The system complies with 21 CFR Part 11 and GMP Annex 11 standards and ensures full traceability through the management of accounts, electronic signatures and audit trails.
Mold detection with AI

In environmental monitoring (EM) classified A, B, C or D, rigorous control ensures and optimizes production compliance.
With a typical counting accuracy of up to 98%, ScanStation avoids false positives and eliminates inaccuracy caused by spread or confluent colonies.
Automate the analysis process

The lack of standardization impacts the analyses, which can have repercussions on the quality of the products. Communication between production and the laboratory is an important factor in making decisions quickly.
Automated environmental monitoring not only ensures compliance with current standards, but also minimizes production interruptions, thus maximizing the profitability and efficiency of operations. By automating repetitive and tedious tasks such as sorting negative/positive plates with batch validation, you free up time for your teams. ScanStation is a flexible solution that allows the analysis to be relocated as close as possible to the sampling sites.